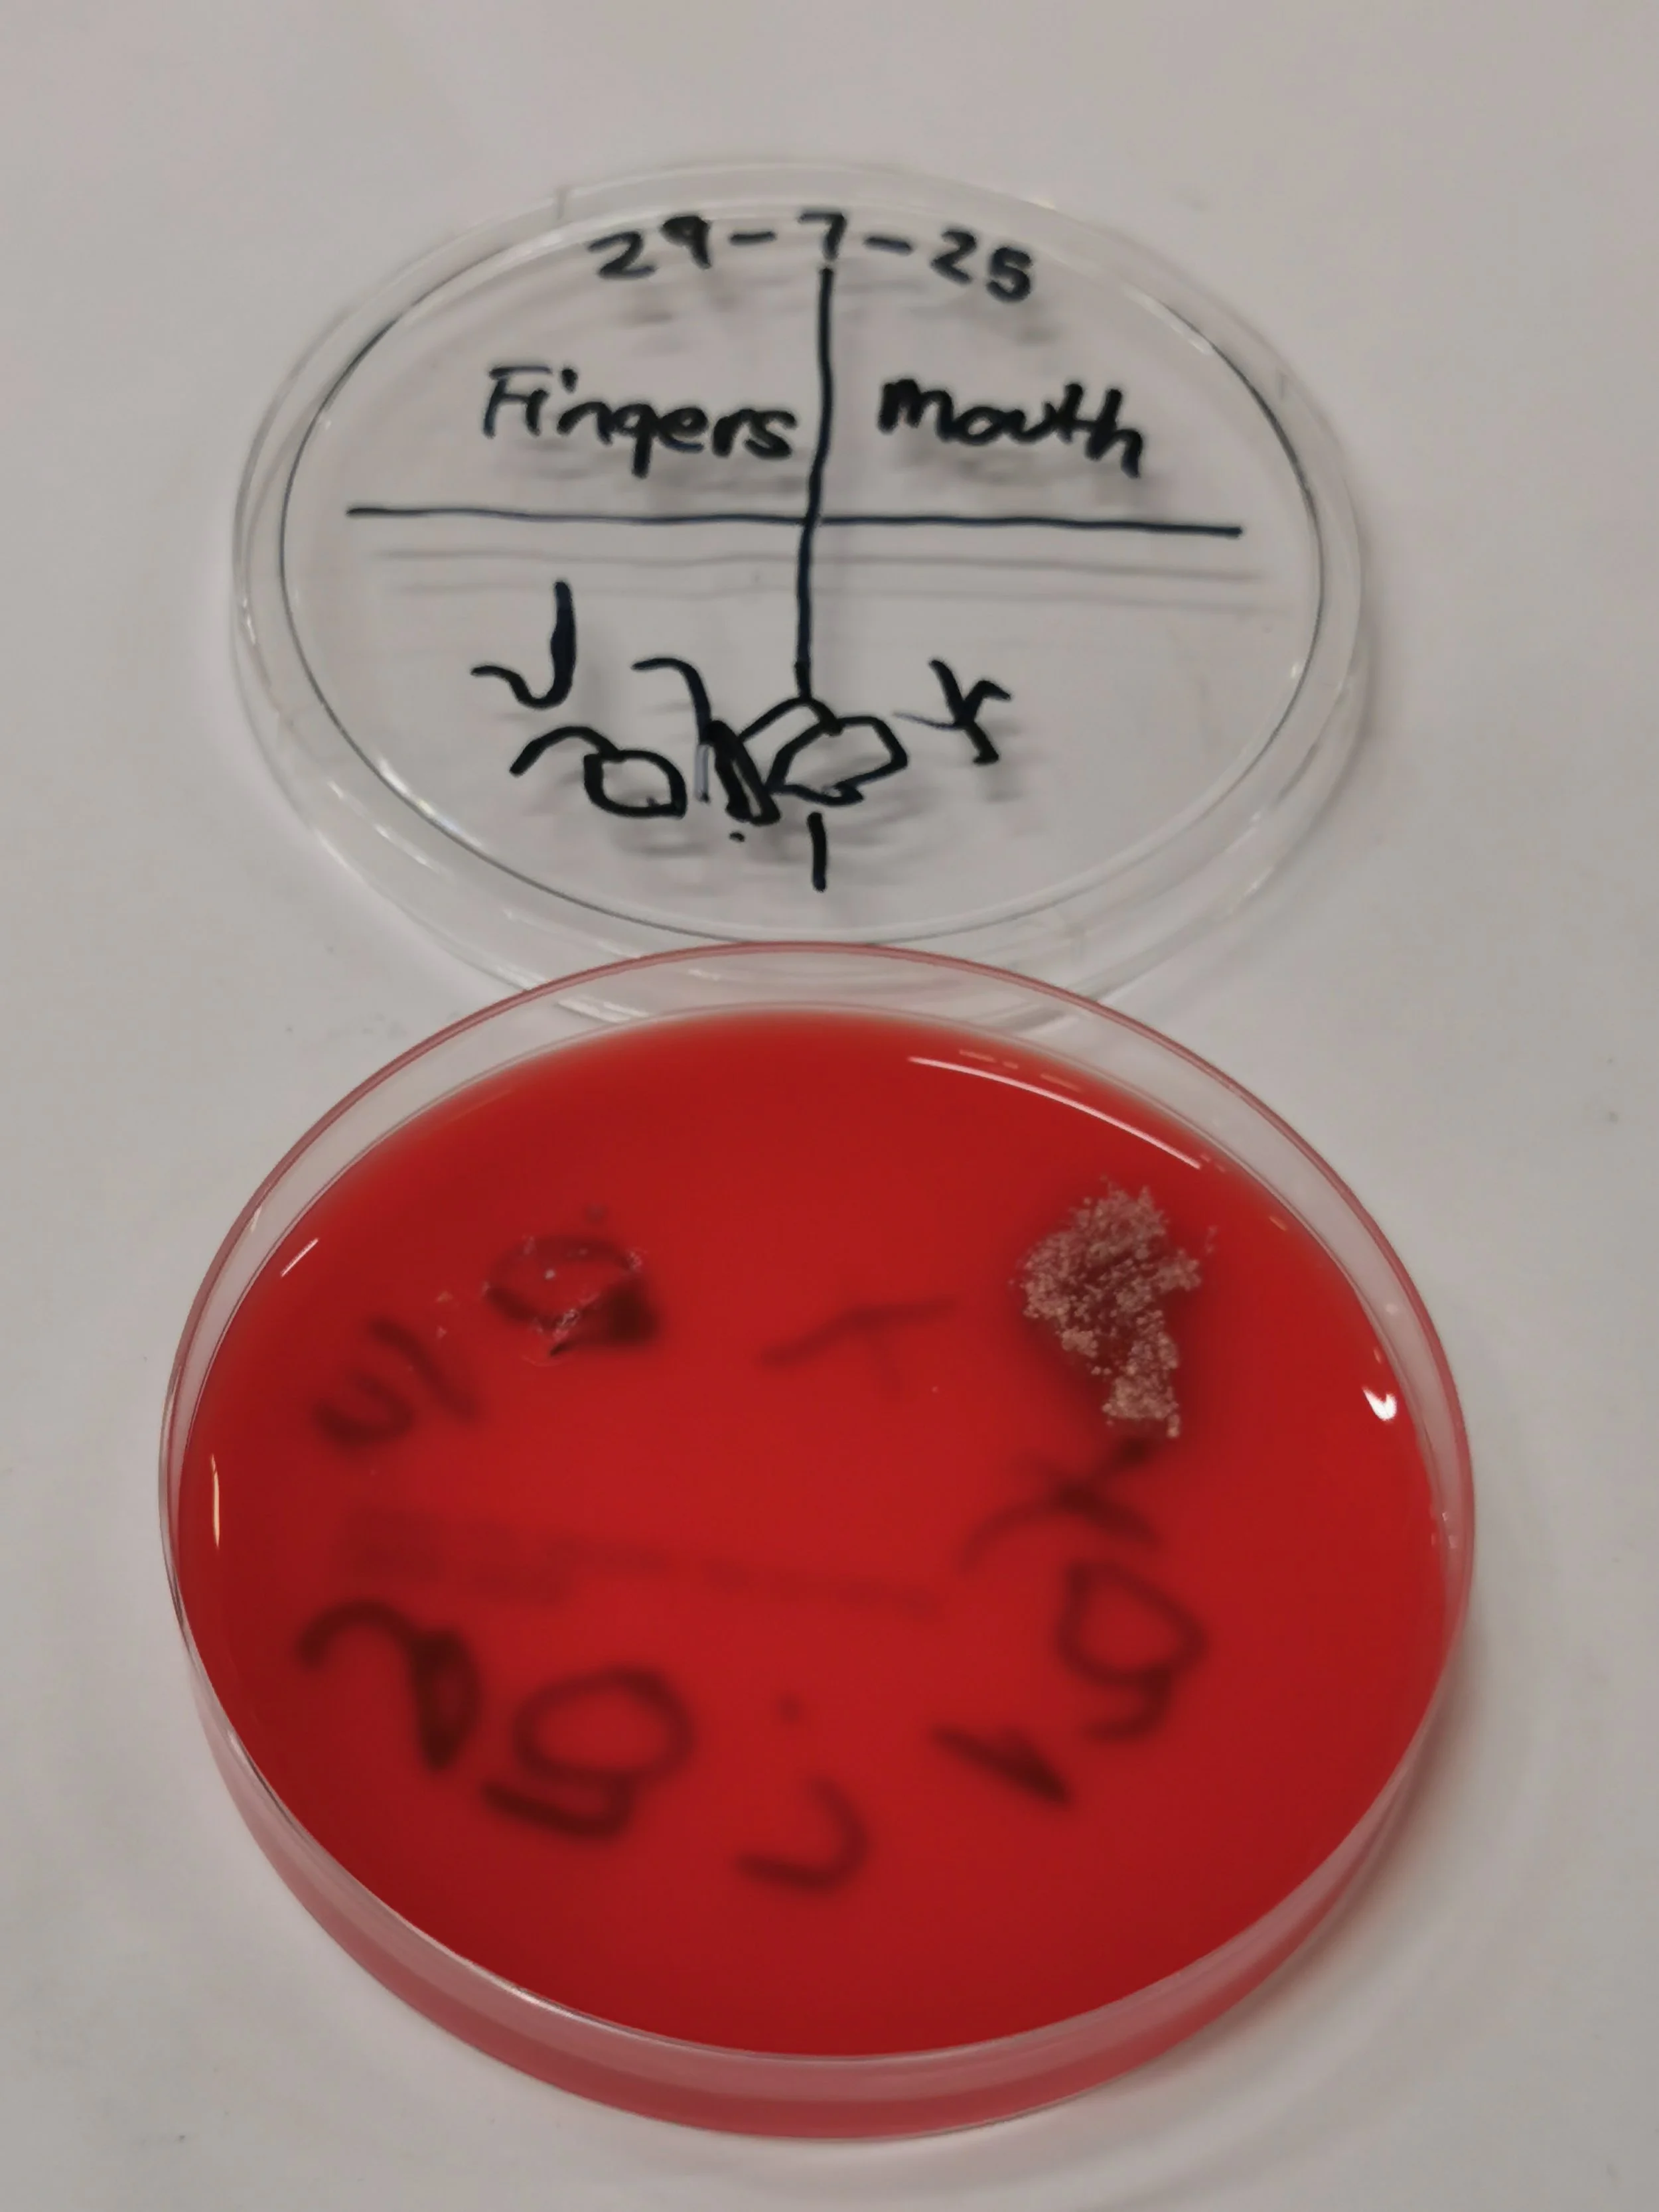
IMG_20250731_144039.jpg

Pop-Up Shop 2025: The results (29th July)
During our event our visitors had the chance to swab their bodies and personal items.
Check out the microbes we grew from tongues, ears, noses, belly buttons, mobile phone screens and much more! 🦠🧫
➡️ Pop-Up Shop 2025
Return to the main event page of our 2025 Pop-Up Shop in Cardiff